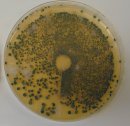

Industrielle arbejdsmiljøer
 En række arbejdsmiljøer frembyder problemer på grund af forhold, der giver mulighed for mikrobiel vækst i arbejdsprocessen. Det kan f.eks. være genbrugsstationer og halm- og flisfyringsanlæg, hvor der spredes store mængder svampesporer, og hvor medarbejdere kan udvikle allergi og allergisk lungebetændelse.
En række arbejdsmiljøer frembyder problemer på grund af forhold, der giver mulighed for mikrobiel vækst i arbejdsprocessen. Det kan f.eks. være genbrugsstationer og halm- og flisfyringsanlæg, hvor der spredes store mængder svampesporer, og hvor medarbejdere kan udvikle allergi og allergisk lungebetændelse.
Skimmelsvampene kan eksempelvis udvikle sig, hvis halmen eller flisen har været våd under lagringen. Ved efterfølgende håndtering spredes der mange svampesporer, der kan indåndes af medarbejdere på arbejdspladsen.
Symptomerne kendes også fra landbruget.
 Det kan være aktuelt at måle luftens indhold af skimmelsvampesporer.
Det kan være aktuelt at måle luftens indhold af skimmelsvampesporer.
Svampelaboratoriet udfører luftanalyser med efterfølgende vurdering af resultaterne i forhold til referenceværdier.
Mængden af svampesporer og sammensætningen af slægter/arter bestemmes som beskrevet under laboratorieundersøgelser.